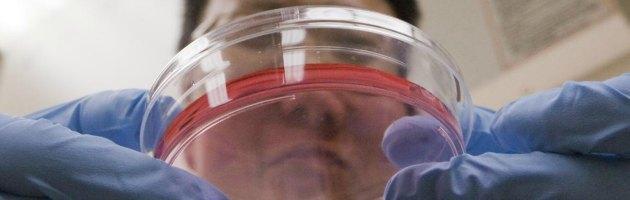

Caso Stamina, continua la polemica. Oggetto delle critiche stavolta è la sperimentazione, che dopo la consegna del protocollo da parte della società torinese all`Istituto superiore di sanità (avvenuta all`inizio di agosto) potrebbe partire in autunno. La commissione di esperti incaricata di individuare modi e luoghi di applicazione della metodica si riunirà nei prossimi giorni a Roma. Ma mentre sembra aprirsi lo spiraglio che consentirà di comprendere davvero se il discusso metodo di cura con le cellule staminali mesenchimali, ovvero del midollo osseo, sia attendibile o meno, le perplessità sulla sperimentazione vengono manifestate da entrambe le parti e con motivazioni ovviamente diverse.
Da una parte c`è Davide Vannoni, il presidente di Stamina foundation, che affidandosi alla solita modalità dei messaggi su facebook, si dice poco convinto che la sperimentazione possa essere applicata su larga scala: il suo ragionamento è che per la fase III, ovvero quella dell`applicazione clinica, ci vorrà per forza l`appoggio di una casa farmaceutica e questo a detta di Vannoni non consentirebbe l`applicazione «di massa» profilata invece da sempre dalla onlus torinese attraverso il ricorso alla modalità di applicazione secondo le cure compassionevoli. Dall`altra c`è una lettera aperta pubblicata domenica sul Sole 24 ore a firma di alcuni esperti – tra cui Gilberto Corbellini e Antonio Musrò, professori de La Sapienza -, che attacca Stamina come una «tragica farsa» chiedendo di desistere dal proseguire nel proprio lavoro ai membri della Commissione ricordando l`inchiesta di Torino in cui la onlus è coinvolta e i dati dell`ispezione di Brescia con cui l`Aifa ha giudicato il laboratorio inadeguato a questo tipo di coltura cellulare.

L’Associazione Luca Coscioni è una associazione no profit di promozione sociale. Tra le sue priorità vi sono l’affermazione delle libertà civili e i diritti umani, in particolare quello alla scienza, l’assistenza personale autogestita, l’abbattimento della barriere architettoniche, le scelte di fine vita, la legalizzazione dell’eutanasia, l’accesso ai cannabinoidi medici e il monitoraggio mondiale di leggi e politiche in materia di scienza e auto-determinazione.